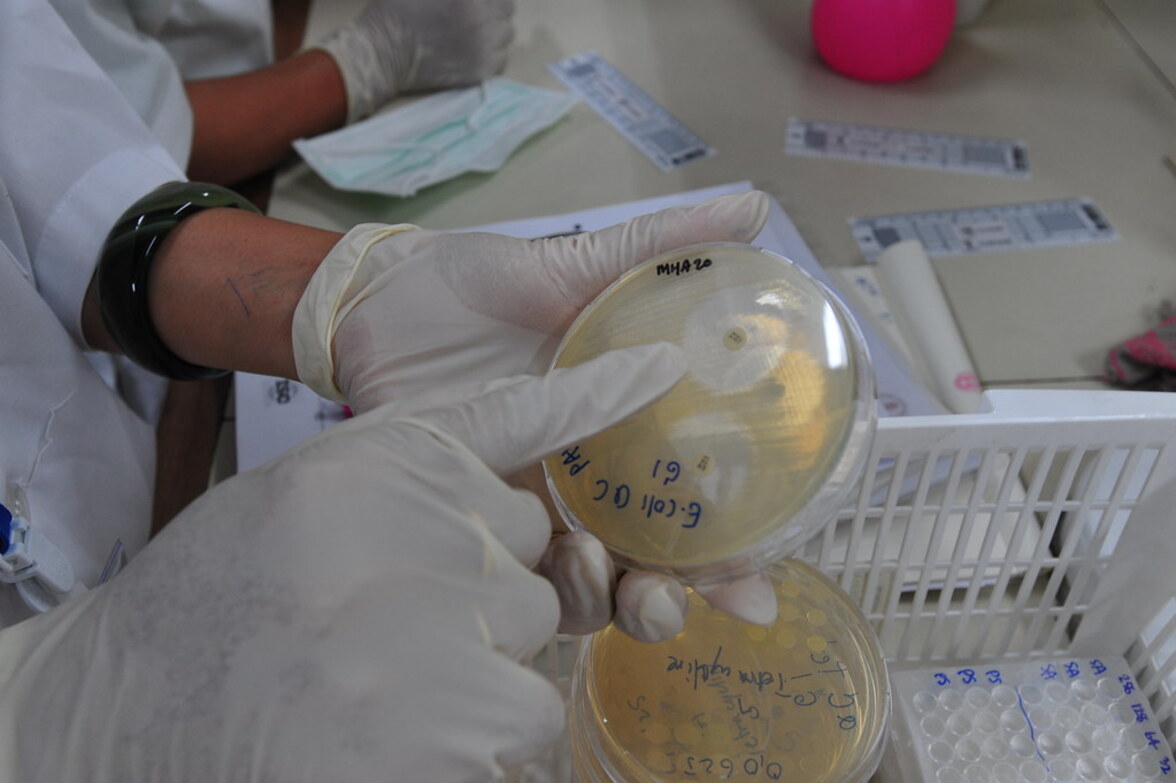
Миллионы людей умирают от инфекций, резистентных к лекарственным препаратам, говорится в глобальном отчете

В 2019 году в мире умерло более 1,2 миллиона человек от инфекций, вызванных бактериями, резистентными к антибиотикам, согласно крупнейшему на сегодняшний день исследованию этой проблемы.
Это больше, чем ежегодное число смертей от малярии или СПИДа (СПИД стал причиной 860 000 смертей, малярия - 640 000). Бедные страны страдают больше всего, но резистентность к противомикробным препаратам угрожает здоровью каждого, говорится в отчете. Для защиты от нее рекомендуется срочно инвестировать в новые препараты и более разумно использовать существующие. Чрезмерное использование антибиотиков в последние годы для лечения банальных инфекций означает, что они становятся менее эффективными против серьезных инфекций.
Представители здравоохранения Великобритании недавно предупредили, что резистентность к противомикробным препаратам (AMR) является "скрытой пандемией", которая может возникнуть после Covid-19, если антибиотики не будут назначаться ответственно.
Оценка количества смертей в мире от AMR, опубликованная 19 января в журнале Lancet, основана на анализе 204 стран, проведенном группой международных исследователей под руководством Вашингтонского университета (США). По их подсчетам, в 2019 году до пяти миллионов человек умерли от болезней, в развитии которых сыграл роль АМР, помимо 1,2 миллиона смертей, вызванных им напрямую.
Большинство смертей от AMR были вызваны инфекциями нижних дыхательных путей, такими как пневмония, и инфекциями кровотока, которые могут привести к сепсису. Особенно смертоносным был MRSA (метициллин-резистентный золотистый стафилококк), E. coli и некоторые другие бактерии также были связаны с высоким уровнем лекарственной резистентности. На основе анализа историй болезни пациентов, результатов исследований и других источников данных, авторы утверждают, что наибольшему риску подвергаются маленькие дети: примерно каждая пятая смерть, связанная с AMR, приходится на детей младше пяти лет.
По оценкам, смертность от AMR:
- самая высокая в странах Африки к югу от Сахары и Южной Азии - 24 смерти на каждые 100 000 человек;
- самая низкая в странах с высоким уровнем дохода - 13 смертей на каждые 100 000 человек;
Профессор Крис Мюррей из Института показателей и оценки здоровья при Университете Вашингтона отметил, что новые данные показывают истинные масштабы резистентности к противомикробным препаратам во всем мире и являются четким сигналом о необходимости немедленных действий, "если мы хотим быть впереди в гонке против резистентности к противомикробным препаратам".
Другие эксперты говорят о необходимости более тщательного отслеживания уровня резистентности в разных странах и регионах. Раманан Лаксминараян из Центра динамики, экономики и политики заболеваний в Вашингтоне считает, что глобальные расходы на борьбу с АМR должны вырасти до уровня, характерного для других заболеваний.
"Расходы должны быть направлены на профилактику инфекций в первую очередь, обеспечение надлежащего и разумного использования существующих антибиотиков, а также на вывод на рынок новых антибиотиков",
- отметил он. Лаксминараян добавил, что большая часть мира сталкивается с проблемой плохого доступа к недорогим и эффективным антибиотикам, и это должно быть серьезно воспринято политиками и руководителями здравоохранения во всем мире.